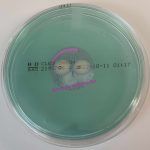
Cled Agar

BLOG
Hallo ihr Lieben, ich heiße Jane und bin Chemikerin, Mikrobiologin und Infektionsepidemiologin. Hier gibt es lauter spannende Beiträge aus der Welt der medizinischen Mikrobiologie. Außerdem plaudere ich auch ein wenig über dies und das, was ich gerade so treibe und was es so Neues gibt. Also schaut euch einfach mal um.
Neueste Beiträge
Interessantes aus der Mikrobiologie
Neues von mir
Newsletter
Erhalte exklusive Rabattaktionen, aktuelle Informationen über neue Kurse und interessante Informationen rund um das Thema medizinische Mikrobiologie – abonniere noch heute meinen Newsletter!